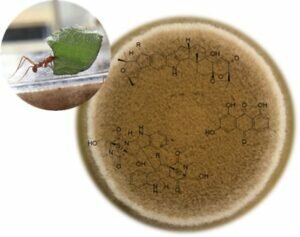

Hello, my name is Dr Claudio Greco and I work in the field of natural products produced by fungi.
I am particularly interested in understanding how microorganisms synthesise these complex molecules and their ecological role. This knowledge could help solve big problems such as antimicrobial resistance and have several applications in food, agrochemical, and pharmaceutical industries.
My research aims to identify novel bioactive natural products produced by fungi that have evolved in competitive environments, these fungi have been relatively understudied yet have the potential to produce many bioactive secondary metabolites.
Research Programme
I have three overarching goals in my research programme:
(I) identifying natural products produced by several fungal species and investigating their biological and ecological role.
(II) Investigating the biosynthesis of secondary metabolites.
(III) Developing new ways to activate biosynthetic gene clusters.
Anti-infective discovery from competitive ecosystems
Currently I am working on my BBSRC Discovery Fellowship titled ‘Anti-infective discovery from competitive ecosystems’ and this will end in April 2024. The main focus of the fellowship is Escovopsis weberi, a pathogenic filamentous fungus that has co-evolved with leaf-cutter ants, their garden fungus Leucoagaricus gongylophorus, and mutualistic Pseudonocardia bacteria. To establish itself and survive in this complex microbiome, E. weberi utilises bioactive secondary metabolites.

Recent work identified some of these compounds and analysis of the genome revealed numerous additional biosynthetic gene clusters suggesting a vast array of cryptic secondary metabolites remain to be discovered. At present, many of these potentially valuable compounds are out-of-reach as no genetic tools have been developed for Escovopsis species.
This project will be a step towards identifying new and effective antibiotics and further demonstrate the importance of natural product research using fungi isolated from complex ecosystems. Results will also yield a better understanding of the leaf-cutter ant ecosystem and provide chemical and genetic tools that could also be applied to other microbiomes.
The Natural Products BioHUB
Dr Claudio Greco is part of the Natural Products BioHUB team. The Natural Products BioHUB is a Swansea University collaboration with Swansea City Council to bring together academia, industry, and the community in supporting research, development and business growth of the region’s Natural Product Sector.
Awaiting Welsh translation.


